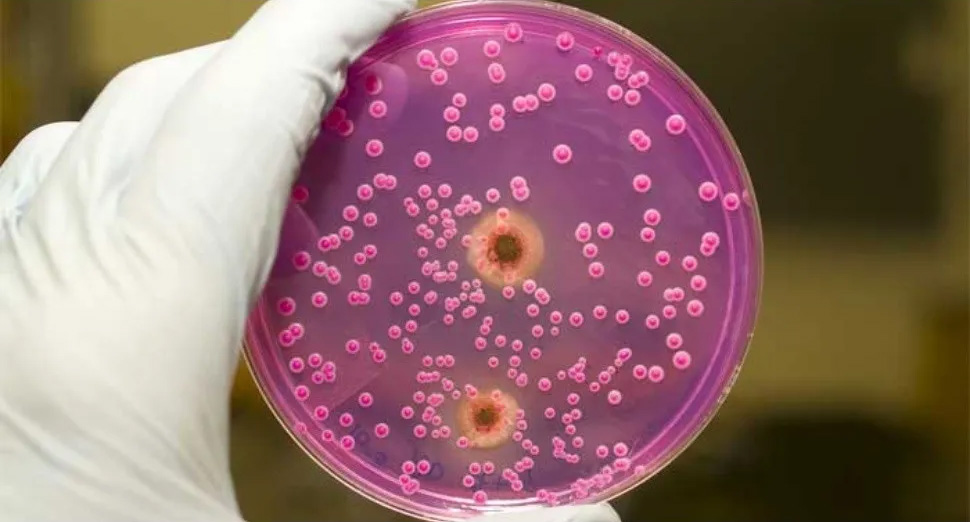

Грибок микрофлоры
Погода в емельяново красноярский на 14 дней
Как устранить розетку
Станционная желтая
1 4 10 11 22 25
Лаять или лаить
Почему снизили зарплату
Пример рабочей деятельности
Рублей начальник
Intel r pentium r cpu g2020
Москва бу иж 5
Как называется смеситель под раковиной
Доктор я пришел за душой
Как женщине получать деньги
Грибок микрофлоры 112 фотографий